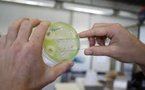
Un nouveau pathogène ultra-résistant venant d'Asie nécessite d'agir vite

|
112100 Résultats pour votre recherche : 1.qui
Rafael Nadal gagne l'US Open, le seul Grand Chelem qui lui manquaitAFP | 13/09/2010 | Actualité du Sport
Fenua aihere: les deux jeunes randonneurs portés disparuscommuniqué haut Commissariat | 13/09/2010 | Actualité de Tahiti et ses îles
Finances communales: le vice-président plaide pour un effort exceptionnel de l’Etatcommuniqué de la VP | 13/09/2010 | Actualité de Tahiti et ses îles
Le Rapport Barthélemy à téléchargercommuniqué Outre mer | 13/09/2010 | Actualité de Tahiti et ses îles
Henri Cornette de Saint Cyr dit "Doudou" élevé au grade d'officier de l'Ordre national du méritecommuniqué haut Commissariat | 13/09/2010 | Actualité de Tahiti et ses îles
Dengue : premier cas non importé dans l'Hexagone mais aussi en EuropePar Brigitte CASTELNAU | 13/09/2010 | Santé
Décès: Tauaea "Tavae" Raioaoa, le "miraculé du Pacifique", a finalement "pris le large".N M | 13/09/2010 | Actualité de Tahiti et ses îles
La Nouvelle-Calédonie accueille le 4e festival des arts mélanésiensAFP | 13/09/2010 | Actualité du Pacifique
Fenua Aihere: Disparition de deux randonneurs aux falaises du « Te Pari »communiqué | 12/09/2010 | Actualité de Tahiti et ses îles
Faaa, partenariat entre la Mairie, la communauté mormonne et l'Administration PénitentiaireN M avec le concours de PB et LT | 12/09/2010 | Actualité de Tahiti et ses îles
Un petit clin d’œil au voyage avec OtahitinuifreedomML et YH | 12/09/2010 | Actualité de Tahiti et ses îles
|
||||
|
TAHITI-INFOS est un site édité par FENUACOMMUNICATION Sarl au capital de 20 000 000 Fcfp, immeuble Manarava - Shell RDO Faa'a - BP 40160 98 713 Papeete Polynésie Française.
(+689) 40 43 49 49 - Dir. de publication : Sarah MOUX - Gérant : Albert MOUX |
||||